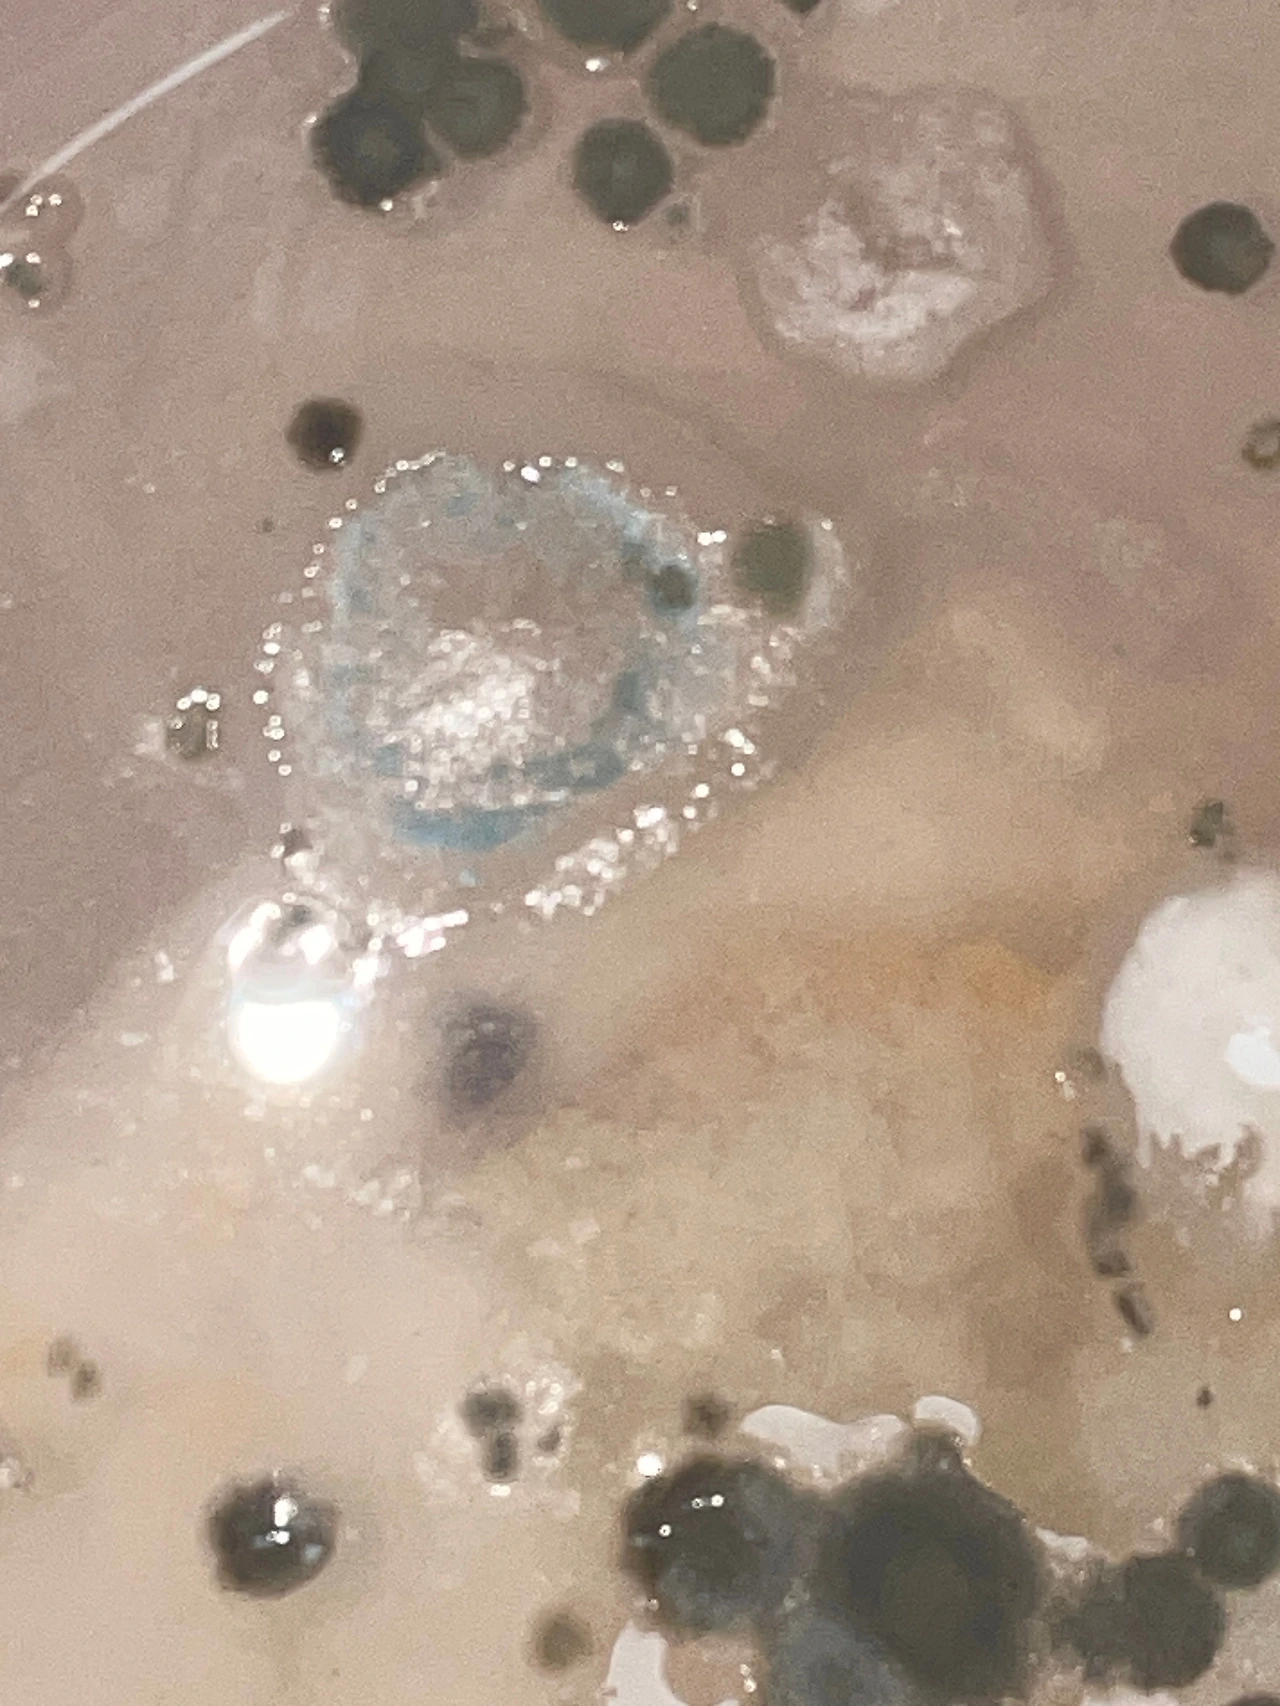
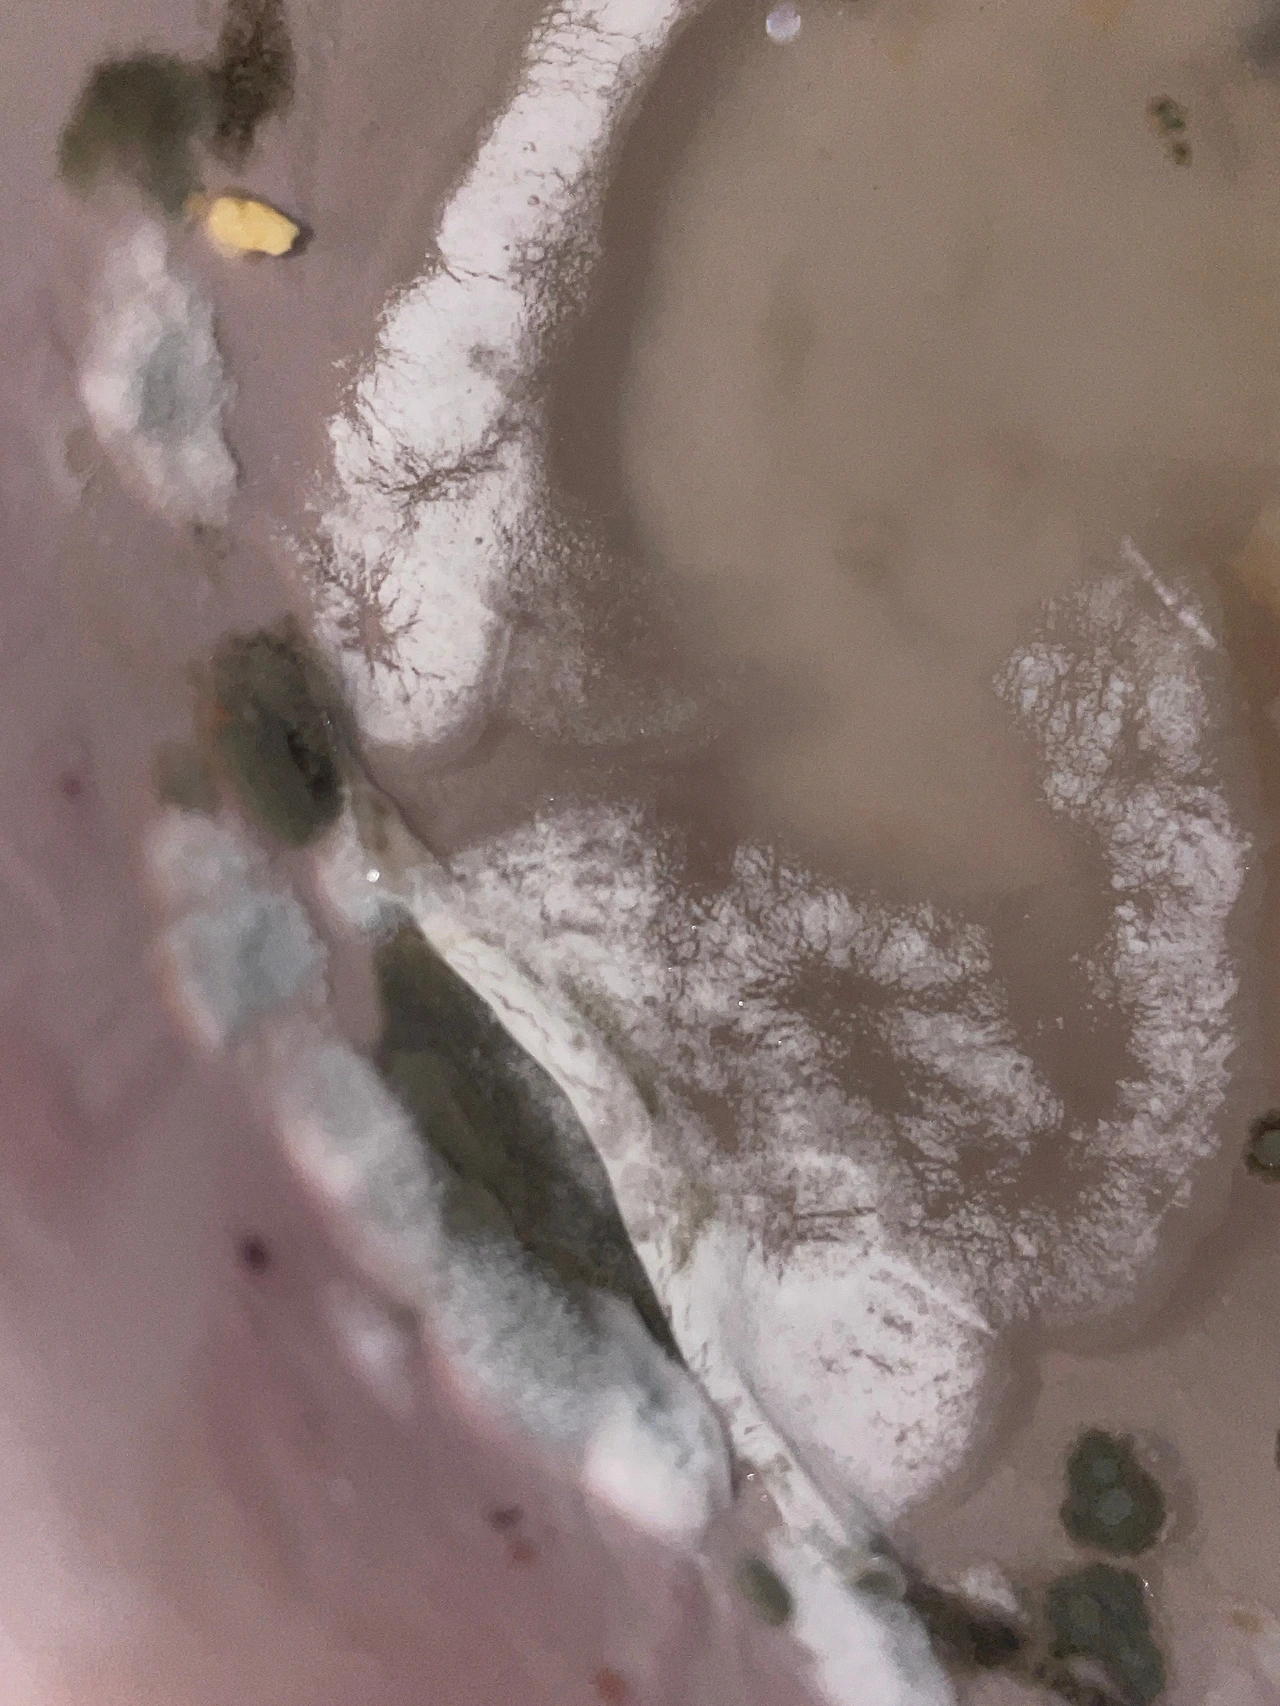

익명사서함, 1
연필선 잘 쓰는 방법
by
Nov 4. 2024
유독 눈앞에 보이는 모든 게 선으로 물감으로 보이는 달이다.
소묘를 처음 배우는 아이들에게 이런 자료들을 보여주면 조금 더 쉅게 배울 것이다. 여기저기 널려 있는 그림들을 보는 게 행복하기도 하다. 그런디..요즘은 선을 쓰는 모든 방법들이 사실은 세상 온천지에 담겨 있다는 것을 느끼면서 고통스러울 때도 있고 담담하게 느껴지기도 한다. 특히 아름답고 귀한 것들이 초라한 것을 압도해 버겁게 느껴진다.
-서대문구 입시 중독자-